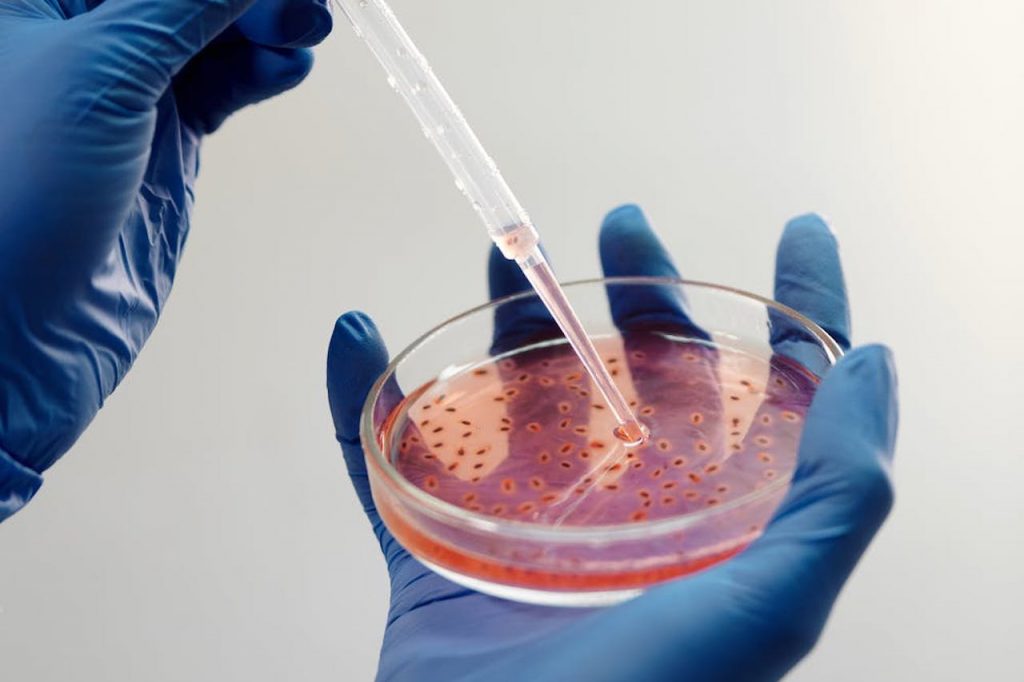

Volatile Organic Compounds Testing Service
PROFILING & CONFIRMATION Food & Beverage Flavor – Aroma Analysis Environment Cosmetic Material Emission – Migrable, Leachable O/MS for Key Ocorant Compounds Character Note Identification VOCS QUANTITATION Environment Cosmetic Food & Beverage Electronics Polymer FOLLOW STANDARD ISO 15189 (Medical Laboratories – Requirement for quality and competence) Laboratory Accreditation: LA Laboratory Standard